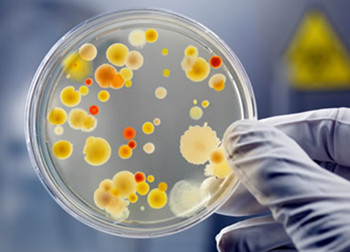
4.jpg

5个问题,带你复习感染性心内膜炎诊治要点
医脉通编译整理,未经授权请勿转载。
近年来,感染性心内膜炎
的患病率呈持续上升趋势,从少见病转变为较常见的心血管疾病
。感染性心内膜炎的发生是一个复杂过程,包括受损的心瓣膜内膜上可形成非细菌性血栓性心内膜炎,瓣膜内皮损伤处聚集的血小板形成赘生物,菌血症
时血液中的细菌黏附于赘生物并在其中繁殖,病原菌与瓣膜基质分子蛋白及血小板相互作用等。感染性心内膜炎可引起瓣膜功能不全、难治性充血性心衰
和心肌脓肿,其诊断和治疗仍是一个挑战。关于这种疾病,你了解多少?来测测吧。
1.对于感染性心内膜炎病因的描述,哪项是正确的?
A.自体瓣膜心内膜炎(NVE)的最常见病因是心脏病
">先天性心脏病
B.早期和晚期人工瓣膜心内膜炎(PVE)的细菌学和预后相似,有与NVE类似的亚急性表现
C.总体来说,金黄色葡萄球菌
是感染性心内膜炎的最常见原因,超过一半的病例与潜在的瓣膜病无关
D.铜绿假单胞菌
是静脉药物滥用(IVDA)感染性心内膜炎的最常见病原体

答案:C
解析:
总体而言,金黄色葡萄球菌感染是感染性心内膜炎的最常见原因,包括PVE、急性感染性心内膜炎和IVDA感染性心内膜炎。大约一半以上的感染性心内膜炎病例与潜在的瓣膜病无关。金黄色葡萄球菌感染性心内膜炎的死亡率为40%~50%。金黄色葡萄球菌感染是院内血行感染的第二常见原因,仅次于凝固酶阴性葡萄球菌
感染。
NVE的主要病因包括:
➤风湿性心脏病
(占NVE的30%)——主要累及二尖瓣,其次是主动脉瓣
➤先天性心脏病(占NVE的15%)——基础疾病包括动脉导管未闭、室间隔缺损、法洛四联症等
➤二尖瓣脱垂伴杂音(占NVE的20%)
早期PVE的细菌学和预后与晚期PVE不同,表现为与NVE相似的亚急性病程。
IVDA感染性心内膜炎最常见的病原体是金黄色葡萄球菌,其中耐甲氧西林金黄色葡萄球菌(MRSA)越来越多见。
2.对于感染性心内膜炎表现的描述,哪项是正确的?
B.脑血管意外
和充血性心力衰竭
是亚急性心内膜炎的常见进展形式
C.大多数亚急性感染性心内膜炎病例是由牙科手术引起的,85%的患者在3~4天内出现症状
D.医院感染性心内膜炎通常表现为脓毒症
,主要发生在人工瓣膜患者

答案:D
解析:
医院感染性心内膜炎通常表现为脓毒症综合征,即低血压、代谢性酸中毒、发热
、白细胞增多和多器官衰竭。其他器官(如肺炎
、肾盂肾炎)或中心静脉导管感染可能是菌血症的来源。医院感染性心内膜炎中有大约45%发生在植入人工瓣膜的患者。
感染性心内膜炎的最常见症状为发热、寒战,其他常见症状包括厌食、体重下降、头痛
、肌肉疼痛、盗汗、短气、咳嗽及关节疼痛等。呼吸困难、咳嗽和胸痛是静脉吸毒者感染性心内膜炎的常见症状。
亚急性心内膜炎可有发热、乏力、厌食、背痛和体重下降等表现,较少发展为脑血管意外或充血性心衰。草绿色链球菌感染
引起的亚急性心内膜炎多与牙病有关,但大多数病例不是由牙科手术引起的,而是由牙龈炎继发的暂时性菌血症引起的,且85%的患者在牙科或其他手术后的2周内出现症状。
3.关于感染性心内膜炎患者的体格检查和相关结果,下列哪项是正确的?
A.多数感染性心内膜炎听诊可闻及心脏杂音
B.多发栓塞性肺部感染和梗死
来自于左心,而全身性脓毒性栓子来自于右心
C.急性感染性心内膜炎患者可并发无菌型脑膜炎
,而亚急性感染性心内膜炎患者可并发化脓性脑膜炎
D.与存在已久的亚急性感染性心内膜炎相比,新近的亚急性感染性心内膜炎更常见到脾肿大

答案:A
解析:
85%的感染性心内膜炎患者心脏听诊可闻及杂音。全身性脓毒性栓子来自左心,更常见于二尖瓣赘生物;而多发栓塞性肺部感染和梗死来自于右心疾病。
急性感染性心内膜炎患者可并发化脓性脑膜炎,而亚急性感染性心内膜炎患者可并发无菌型脑膜炎。存在已久的亚急性感染性心内膜炎患者中更常见到脾肿大。
4.关于感染性心内膜炎的诊断,下列哪项是正确的?
A.存在持续的菌血症足以诊断瓣膜赘生物感染
B.诊断感染性心内膜炎的标准检查是基于血培养
结果的持续菌血症(> 30 min)
C.亚急性心内膜炎常见白细胞增多症,急性心内膜炎常见贫血
D.超声心动图
结果阴性可以排除感染性心内膜炎诊断,包括经食管超声心动图和经胸超声心动图
答案:B
解析:
诊断感染性心内膜炎的标准检查是基于血培养结果的持续菌血症(> 30 min)。连续菌血症的存在并不一定意味着瓣膜赘生物感染。亚急性心内膜炎常见贫血,急性心内膜炎可见白细胞增多症。超声心动图可作为间接诊断方法,特别是在存在感染性心内膜炎临床表现但血培养未能确诊的患者,例如真菌性心内膜炎患者。无论是经胸超声心动图还是经食管超声心动图,检查结果阴性都不能排除感染性心内膜炎。
5.关于感染性心内膜炎的治疗,哪项是正确的?
A.亚急性感染性心内膜炎患者在细菌培养和药敏试验
之前必须接受抗生素治疗,因为随着时间推移并发症风险增加
B.PVE患者应接受利福平
单药一线治疗
C.NVE合并充血性心衰是手术的主要适应证
D.连续输注万古霉素
是耐氨基糖苷类肠球菌感染的最佳治疗方法

答案:C
解析:
大约有15%~25%感染性心内膜炎患者最终需要手术。NVE患者的外科手术指征如下:
➤标准药物治疗难以改善的充血性心衰
➤真菌感染性心内膜炎(特别是荚膜组织胞浆菌)
➤72小时恰当抗生素治疗后的持续性败血症
➤复发性脓毒性栓塞,特别是抗生素治疗2周后
➤主动脉窦动脉瘤
破裂
➤间隔脓肿所致的传导异常
➤主动脉瓣感染性心内膜炎患者二尖瓣前叶亲吻赘生物感染
亚急性感染性心内膜炎患者抗生素治疗可延迟,直到细菌培养和药敏试验结果回报,等待不会增加并发症风险。PVE患者应使用万古霉素或庆大霉素
。连续输注氨苄西林(血清水平为16μg/mL)是耐氨基糖苷类肠球菌感染的最佳治疗方法,替代治疗药物包括亚胺培南、环丙沙星
或氨苄西林/舒巴坦
。
关于感染性心内膜炎,详见>>>2014成人感染性心内膜炎预防、诊断和治疗专家共识
医脉通编译自:Michael Stuart Bronze. Fast Five Quiz: Refresh Your Knowledge on Key Aspects of Infective Endocarditis. Medscape. Dec 05, 2017.